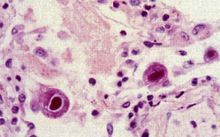
巨細胞病毒

鑑別診斷
生物學性狀
CMV具有典型的皰疹病毒形態,其DNA結構也與HSV相似,但比HSV大5%。本病毒對宿主或培養細胞有高度的種特異性,人巨細胞病毒(HCMV)只能感染人,及在人纖維細胞中增殖。病毒在細胞培養中增殖緩慢,複製周期長,初次分離培養需30~40天才出現細胞病變,其特點是細胞腫大變圓,核變大,核內出現周圍繞有一輪“暈”的大型嗜酸性包涵體。
診斷
巨細胞病毒
巨細胞病毒巨細胞病毒藥品 唾液、尿液、子宮頸分泌液等標本離心沉澱,將脫落細胞用姬姆薩染色鏡檢,檢查巨大細胞及核內和漿內嗜酸性包涵體,可作初步診斷。分離培養可將標本接種於人胚肺纖維母細胞中,由於CMV生長周期長,細胞病變出現慢,為了快速診斷,可將培養24小時的感染細胞固定,用DNA探針進行原位雜交,檢測CMVDNA。用ELISA檢測lgM抗體和lgG抗體,適用於早期感染和流行病學調查。IgG抗體可終身持續存在,lgM抗體與急性感染有關。不論是初次感染或復發感染,當病毒血症時,可用葡聚糖液提取外周血單個核細胞,製成塗片,加CMV單克隆抗體,採用免疫酶或螢光染色,檢測細胞內抗原。套用免疫印跡法和分子雜交技術直接從尿液,各種分泌物中檢測CMV抗原和DNA是既迅速又敏感,準確的方法。CMV感染診斷中應注意的問題:CMV感染的診斷依據詳見CMV感染診斷方案,臨床套用中需注意以下幾方面的問題。
1.對CMV感染的診斷主要依靠實驗室檢查結果,因此實驗室操作從試劑選用至結果判定,都需保證質量。採用國際上尚未公認的新方法時,應與“金標準”病毒分離等結果對照,考核其可靠性。2.在中國小兒中,原發感染大多發生於嬰幼兒時期,此時又多呈產毒型感染狀態。以後隨著年齡增長趨向潛伏感染。但在患有其他疾病時,體內病毒又可被激活,呈現產毒型感染。如人們觀察過3歲以上的53例急性黃疸型A型肝炎,在他們的急性期除2例(3.8%)外均伴有CMV感染,其中半數以上(64.2%)為再發感染,以後隨訪中發現又轉為潛伏感染,可以作為佐證。
3.CMV感染小兒多表現為無症狀性感染,只有少數為症狀性感染,且又多發生於先天性和圍生期感染患兒。在嚴重免疫缺陷時,可出現肺炎、肝炎等全身疾患。
4.CMV感染可累及宿主機體各個器官和系統,但產生嚴重病變的機會不多,靶器官的損害又與患兒的年齡有關。中樞神經系統損害(如小頭畸形、智慧型障礙等)和先天畸形主要見於先天性感染;肝炎、肺炎還可見於嬰幼兒時期感染。因此,在生後感染患兒身上發現有中樞神經損害和先天畸形,將其歸為CMV感染所致是不科學的。
5.新生兒在娩出時,往往會在其體內混入微量母親血液,臍帶血更甚。故從臍帶血或初生新生兒血中用PCR法查得CMVDNA,以示新生兒感染也是不可靠的。應該再次對新生兒複查或作其他病毒學檢查核實。
6.對症狀性CMV感染如肺炎、肝炎的診斷,僅僅依賴血清學或尿、血中病毒學檢查陽性結果也欠妥當。因為這些檢測結果只能表現體內有CMV存在或複製,卻無定位意義。如從病變肺、肝組織中原位檢測陽性則就可靠,但是實施困難。因此,應該採取肺炎患兒的下呼吸道分泌物替代或排除能夠引起同樣病症的其他病因和病原,力求診斷可靠。
類型
1.根據其感染的次序可分為:⑴原發感染(primaryinfection):指宿主初次感染CMV,而在感染前缺乏對CMV的任何特異性抗體(6個月以前的嬰兒可有從母體被動獲得的IgG抗體);⑵再發感染(recurrentinfection),是由於潛伏在宿主體內的病毒被重新激活(reactivation)而複製增殖;或再次感染(reinfection)外源性不同毒株或更大劑量的同株病毒。CMV侵入宿主體內,並在宿主體內複製或潛伏,即為CMV感染。
2.根據宿主獲得感染的時間可分為:⑴先天性感染(congenitalinfection):指由CMV感染的母親所生育的子女,於其出生14天內(含14天)證實有CMV感染,為宮內感染所致;⑵圍生期感染(perinatalinfection):為CMV感染母親的子女,在出生14天內沒有發現CMV感染,而於生後第3~12周內證實感染者,主要經產道或母乳途徑獲得感染。以上兩型都是原發性感染;⑶生後感染(postnatalinfection)或獲得性感染(acquiredinfection):指在出生12周后證實有感染(出生12周內無CMV感染證據),可以是原發感染,也可以為再發感染。人們前瞻性觀察47例由CMV感染母親生育的子女至1周歲,其中先天性感染27.7%,圍生期感染23.7%,生後感染34%,無感染14.6%。但在臨床工作中,由於患兒沒有從出生開始定期作過CMV檢測,因此較晚就診者很難確定為何型感染。有些先天性感染患兒,出生時沒有症狀,以後才出現智慧型減退或耳聾,故應格外重視,予以定期隨訪。3.根據有無症狀出現,又可分為:⑴症狀性感染(symptomaticinfection):指出現與CMV感染相關的症狀和體徵。若CMV損害宿主2個或2個以上的器官、系統時又稱全身性感染(systemicinfection),多見於先天性感染,仍可沿用病理診斷名稱即巨細胞包涵體病(cytomegalicinclusiondisease,CID);若CMV損害主要集中於宿主的某一器官或系統,則可相應地稱為CMV性肝炎(CMVhepatitis)、CMV性肺炎(CMVpneumonia)或傳染性單核細胞增多症(infectiousmononucleosis)等。在症狀性感染時,患兒體內均有病毒活動,處於產毒型感染階段。⑵無症狀性感染(asymptomaticinfection):指體內病毒複製狀態有二種情況:一是有病毒複製,若足以引起靶器官或組織損害,臨床表現有體徵和器官功能改變,稱之為亞臨床型感染(subclinicalinfection);若未引起靶器官損害,則無相應體徵和功能變化,為真正的無症狀性感染。後者是病毒處於潛伏狀態或呈不全感染。
性狀
巨細胞病毒的研究
CMV具有典型的皰疹病毒形態,其DNA結構也與HSV相似,但比HSV大5%。本病毒對宿主或培養細胞有高度的種特異性,人巨細胞病毒(HCMV)只能感染人,及在人纖維細胞中增殖。病毒在細胞培養中增殖緩慢,複製周期長,初次分離培養需30~40天才出現細胞病變,其特點是細胞腫大變園,核變大,核內出現周圍繞有一輪“暈”的大型嗜酸性包涵體。機體的細胞免疫功能對CMV感染的發生和發展起重要作用,細胞免疫缺陷者,可導致嚴重的和長期的CMV感染,並使機體的細胞免疫進一步受到抑制,如殺傷性T細胞活力下降,NK細胞功能減低等。機體原發感染CMV後能產生特異性抗體和殺傷性T淋巴細胞,激活NM細胞。抗體有限CMV複製能力,對相同毒株再感染有一定抵抗力,但不能抵抗內源性潛伏病毒的活化,及CMV其他不同毒株的外源性感染。而通過特異性殺性T淋巴細胞和抗體依賴細胞毒性細胞能發揮最大的抗病毒作用。
防治
綜述
CMV在人群中感染非常廣泛,中國成人感染率達95%以上,通常呈隱性感染,多數感染者無臨床症狀,但在一定條件下侵襲多個器官和系統可產生嚴重疾病。病毒可侵入肺、肝、腎、唾液腺、乳腺其他腺體,以及多核白細胞和淋巴細胞,可長期或間隙地自唾液、乳汗血液、尿液、精液、子宮分泌物多處排出病毒。通常口腔,生殖道,胎盤,輸血或器官移植等多途徑傳播。
(一)先天性感染
妊娠母體CMV感染可通過胎盤侵襲胎兒引起先天性感染,少數造成早產、流產、死產或生後死亡。患兒可發生黃疸,肝脾腫大,血小板減少性紫斑及溶血性貧血。存活兒童常遺留永久必性智力低下,神經肌肉運動障礙,耳聾和脈絡視網膜炎等。
(二)圍產期感染
產婦泌尿道和宮頸排出CMV,則分娩時嬰兒經產道可被感染,多數和症狀輕微或無臨床症狀的亞臨床床感染,有的有輕微呼吸道障礙或肝功能損傷。
(三)兒童及成人感染
通過吸乳、接吻、性接觸、輸血等感染、通常為亞臨床型,有的也能導致嗜異性抗體陰性單核細胞增多症。由於妊娠,接受免疫抑制治療,器官移植,腫瘤等因素激活潛伏在單核細胞、淋巴細胞中病毒,引起單核細胞增多症、肝炎、間質性肺炎、視網膜炎、腦炎等。
(四)細胞轉化和可能致癌作用
經紫外線滅活的CMV可轉化嚙齒類動物胚胎纖椎母細胞。在某些腫瘤如宮頸癌、結腸癌、前列腺癌、Kaposis肉瘤中CMVDNA檢出率高,CMV抗體滴度亦高於正常人,在上述腫瘤建立的細胞株中還發現病毒顆粒,提示CMV與其皰疹病毒一樣,具有潛在致癌的可能性。
免疫性
機體的細胞免疫功能對CMV感染的發生和發展起重要作用,細胞免疫缺陷者,可導致嚴重的和長期的CMV感染,並使機體的細胞免疫進一步受到抑制,如殺傷性T細胞活力下降,NK細胞功能減低等。
機體原發感染CMV後能產生特異性抗體和殺傷性T淋巴細胞,激活NM細胞。抗體有限CMV複製能力,對相同毒株再感染有一定抵抗力,但不能抵抗內源性潛伏病毒的活化,及CMV其他不同毒株的外源性感染。而通過特異性殺性T淋巴細胞和抗體依賴細胞毒性細胞能發揮最大的抗病毒作用。
微生物學診斷
唾液、尿液、子宮頸分泌液等標本離心沉澱,將脫落細胞用姬姆薩染色鏡檢,檢查巨大細胞及核內和漿內嗜酸性包涵體,可作初步診斷。
分離培養可將標本接種於人胚肺纖維母細胞中,由於CMV生長周期長,細胞病變出現慢,為了快速診斷,可將培養24小時的感染細胞固定,用DNA探針進行原位雜交,檢測CMVDNA。
用ELISA檢測lgM抗體和lgG抗體,適用於早期感染和流行病學調查。IgG抗體可終身持續存在,lgM抗體與急性感染有關。
不論是初次感染或復發感染,當病毒血症時,可用葡聚糖液提取外周血單個核細胞,製成塗片,加CMV單克隆抗體,採用免疫酶或螢光染色,檢測細胞內抗原。
近年套用免疫印跡法和分子雜交技術直接從尿液,各種分泌物中檢測CMV抗原和DNA是既迅速又敏感,準確的方法。
防治原則
丙氧鳥苷(ganciclovirDHPG)有防止CMV擴散作用。如與高滴度抗CMV免疫球蛋白合用,可降低骨髓移植的CMV肺炎併發症死亡率,如果耐丙氧鳥苷的CMV感染可選用磷甲酸鈉,雖能持久地減少CMV擴散,但效果比前者差。國外研製CMV病毒活疫苗,能誘導產生抗體,但排除疫苗的致癌潛能,有待解決
預防保健
⑴進行有意識的身體素質的鍛鍊。提高機體免疫機能及抗病能力,特別是育齡期婦女,以減少巨細胞病毒對胎兒的嚴重危害。
⑵對於孕婦或有慢性消耗性疾病、免疫力低下等患者要注意保護,使她們遠離傳染源。
⑶注意環境衛生、飲食衛生。
⑷乳汁中巨細胞病毒陽性者,不應哺乳。
⑸免疫防治,尚在研究和探索中。 CMV引起細胞內感染後,滅活疫苗無明顯預防的作用。懷孕早期發現有CMV原發感染及/或羊水細胞中有CMV抗原時,應中止妊娠。減毒活疫苗可使被接種者產生抗體。並產生對CMV的細胞免疫,減少症狀性CMV感染的發生。CMV高價免疫球蛋白對血清CMV陰性的骨髓移植受者的症狀性CMV感染,有一定的保護作用,但不能預防再感染。在接觸患兒尿液或唾液後應仔細洗手,以預防後天性CMV感染。
預防輸新鮮血引起的CMV感染,可用下列方法:①使用冷凍血液或經沖洗的血液;②血液輸入前須貯存48小時以上;③使用經放射線照射過的血液;④使用血液濾器除去血液中的巨細胞。
治療
愛滋病人巨細胞病毒
由於CMV感染患者大多處於潛伏感染狀態;即使CMV在體內複製活動,也多為無症狀性感染。目前又無有效、安全的抗CMV藥物,故對CMV感染的治療,仍限於症狀性感染時的對症處理;更昔洛韋因有骨髓抑制等毒副作用,因此只能在症狀性感染時謹慎使用。丙氧鳥苷(ganciclovirDHPG)有防止CMV擴散作用。如與高滴度抗CMV免疫球蛋白合用,可降低骨髓移植的CMV肺炎併發症死亡率,如果耐丙氧鳥苷的CMV感染可選用磷甲酸鈉,雖能持久地減少CMV擴散,但效果比前者差。國外研製CMV病毒活疫苗,能誘導產生抗體,但排除疫苗的致癌潛能,有待解決。
春季易發疾病大點兵
| 春季是很多疾病肆虐的時間,這些疾病都是可以預防的,早知道,早預防,早發現,讓疾病遠離我們,擁有一個健康的春天。 |

